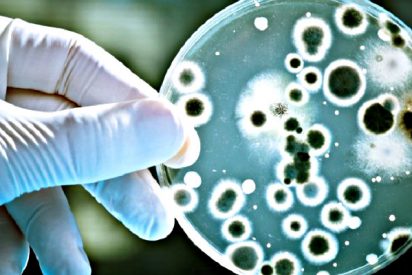
Un extracto del ar&aacute;ndano hace que las bacterias sean m&aacute;s sensibles a los antibi&oacute;ticos

Espinosa de los Monteros silencia a Chaparro: «Yo tampoco veo que condenéis las agresiones a militantes de VOX»
Carlos Herrera carga contra los «gilipollas» que se rieron de la mujer del vídeo porno y que la empujaron al suicidio
Carlos Herrera no ha obviado este 29 de mayo de 2019 en su editorial de ‘Herrera en COPE' la espeluznante noticia de la trabajadora de Iveco que se quitó la vida el fin de semana del 25-26 de mayo de 2019 debido a la filtración de un vídeo suyo de contenido sexual al parece grabado hace cinco años cuando estaba con una pareja diferente a la actual -Una joven madre
Lo que decía Doña Sofía en 2008: «El Rey no abdicará jamás, nunca ha entrado en nuestro planes»
Hace ya mucho tiempo de estas palabras de la reina. Doña Sofía daba su opinión acerca de si su marido debía abdicar o jubilarse ya en 2008, a la periodista Pilar urbano. La Reina fue muy contundente acerca del asunto, según recoge Silvia Armesto en informalia. Con motivo del 70 aniversario de la Reina Sofía, en octubre de 2008, la escritora actualizó
El ridículo espantoso que hace Mamen Mendizabal tratando de burlarse de Esperanza Aguirre, Díaz Ayuso y El Pecas: «¡Qué disgusto me está dando!»
La pregunta era pertinente por parte de Mamen Mendizabal, por la rumorología desatada en las redes sobre si Isabel Díaz Ayuso había sido la community manager del Pecas, el perro de Esperanza Aguirre. Lo que no fue pertinente es lo que vino después. Lo confirmó la expresidenta de la Comunidad de Madrid, este 28 de mayo de 2019 en 'Más Vale Tarde' de laSexta,
El esbirro de ‘Don Piso’ hace publicidad de una casa okupada en ‘El Intermedio’ de laSexta
El Quilombo / Programa completo del 29 de Mayo del 2019
Mila Ximénez pedirá que embarguen judicialmente a Makoke por los 6.000 euros que le debe
De todo el mundo que sigue 'Sálvame' es concodia la animadversión que se tienen Mila Ximénez y Makoke. Hasta tal punto que las dos se han visto en los Juzgados. Fruto de esas rencillas judiciales hay una deuda a favor de la ex mujer de Manolo Santana por la que la exmujer de Kiko Matamoros tiene que abonarle 6.000 euros. Mila Ximénez imitaba la forma en que Makoke responde
‘El Intermedio’ de Wyoming blanquea el movimiento ‘okupa’ de Madrid mientras que su jefe tiene casas e inmuebles a cascoporro
"Aquí solo vienen las personas que respeten los derechos humanos, es decir, no se permiten conductas machistas ni racistas." Reportaje 'publicitario' en 'El Intermedio' sobre 'La Ingobernable', uno de los emblemas del movimiento 'okupa' de Madrid.--Twitter ajusta cuentas y despedaza a los defraudadores Bardem y 'Don Piso'-- Según ellos, este antiguo centro cultural ahora 'okupado' es
Parejas: el amor frecuente y los rollos sexuales de la oficina
Amor en el trabajo, ¿realidad o ficción? En la teoría hemos aprendido que el trabajo y la vida personal deben ir por separado. Pero claro, llevarlo a la práctica es un poco más complicado… O al menos así lo revela un estudio realizado por InfoJobs, que estima que 3 de cada 10 españoles han mantenido una relación de pareja con un compañero de trabajo. En tu entorno de trabajo compartes muchas
Adrián Rodríguez, de la gloria a la ruina: así destroza ‘SV’ la vida de sus concursantes
Adrián Rodríguez es el claro ejemplo de juguete roto televisivo. El cantante y actor de series como ‘Física o Química', fue una auténtica estrella hace años pero apareció en ‘Supervivientes 2018' y , al parecer, arruinó su carrera. Así lo contó él mismo el martes 28 de mayo de 2019. Adrián Rodríguez
Este hombre ve a un bebé a cayendo desde un 5º piso y lo salva en el último segundo colocándose debajo
Una cámara de vigilancia registró el pasado jueves el momento en que un vecino de la ciudad china de Yining salvó la vida de un bebé de dos años que cayó desde un 5 piso, informa el portal CCTV Plus, según rt. El hombre, de 28 años, se percató de la situación desde el interior de su vehículo y, gracias a sus rápidos
Madrid devuelve la dignidad a la derecha
Aunque muchos sigan apesadumbrados por todo lo que se nos viene encima tras el FRAUDE ELECTORAL del 28-A, silenciado por la totalidad de la prensa oficialista, yo quiero mostrar la euforia que me acaba de llegar envuelta en papel de regalo. No lo esperaba. Quizá porque, en el fondo, pensaba que intentarían repetir la jugada del algoritmo y los múltiplos –con alguna variante— que tanto está
Belén Esteban ha contratado algo muy raro para su boda…
Belén Esteban ha contratado algo muy peculiar para su boda…
Las revistas del corazón vuelven, como cada miércoles, para sorprendernos con sus mejores contenidos. 'HOLA' habla de la boda del verano, muy probablemente del año, entre Carlota Casiraghi y su chico Dimitri Rassam del próximo sábado. Bertín Osborne y Fabiola continúan luchando por la vida de su hijo Kike y Sara Carbonero recibe el alta y reconoce que todavía le quedan unos meses de tratamiento.
La hija de Terelu Campos posa sin maquillaje y descubrimos que…¡es una adolescente más!
Desde que apareciera publicamente portagonizando junto a su madre Terelu Campos la portada de la revista ¡HOLA! cuandoo cumlión los 18 años, nunca habíamos visto a Alejandra Rubio posar sin estar maquillada. Pero ahoa la joven 'influencer' ha decidido mostrar su rostro al natural y ha compartido con sus seguidores de su canal de mtmad (Mediaset) sus secretos de belleza diarios.
Macizas: «¿Qué es el efecto Kardashian?»
Puede que en Estados Unidos y Sudamérica Kim Kardashian sea el ideal estético: labios, pómulos, pecho y glúteos XL junto a una cintura de avispa, en la línea del über Body y la Pillow Face. En cambio en España la Medicina Estética apuesta por la proporción y solo el 5% demanda este look. El Dr. Cerrud revela todos los aspectos del fenómeno. P: ¿Dr. Cerrud, en qué consiste el efecto Kardashian?
Lidia: Gonzalo Caballero da sus primeros pasos después de la grave cogida
Gonzalo Caballero ha colgado en su perfil de Instagram un vídeo que ha alegrado a todos los seguidores que siguen muy pendientes por su estado de salud tras la cogida que sufrió hace apenas una semana. En él, podemos ver como el torero, con ayuda de dos muletas, va dando pasos cortos y lo cierto es que no esperábamos para nada que en tan solo una semana pudiésemos
Así fueron los cinco días de pánico, burlas y vejaciones a Verónica hasta que se ahorcó
Se lo contábamos este martes en Periodista Digital, Verónica Rubio, de 32 años y madre de dos niños de 4 y 9 meses, trabajadora de la fábrica de camiones CNH Industrial, propiedad del grupo Iveco, en Madrid, se quitaba la vida después de que sus compañeros compartiesen un vídeo sexual que al parecer la propia mujer
Los Secretos celebrarán su 40º aniversario en el Universal Music Festival 2019
Los Secretos, uno de los nombres clave en la historia del pop en castellano, fue pieza fundamental en la renovación de dicho género desde su fundación en los primeros días de nuestra Nueva Ola. El grupo madrileño, que lleva cuatro décadas construyendo una trayectoria cabal, tachonada de canciones perdurables que se han integrado en nuestro acervo cultural,
Investigadores españoles logran aumentar la eficiencia de CRISPR para destruir oncogenes de células cancerosas
Investigadores del Centro de Investigación del Cáncer (CIC-IBMCC) y de la Universidad de Salamanca han logrado mejorar la eficacia de destrucción del sistema CRISPR/Cas9 para destruir genes y oncogenes en células con cáncer. Al testar esta técnica en ratones, han conseguido destruir específicamente uno de los genes responsables de la pigmentación,
José Coronado se olvida de Isabel Pantoja en su favorito de ‘Supervivientes’
José Coronado y su hijo Nicolás no quisieron perderse la cita más solidaria del verano en el Teatro Real de Madrid. Allí, ambos actores disfrutaron del concierto 'Acordes con Solidaridad' de Ayuda en Acción, dirigido por el director de orquesta Pablo Heras-Casado. Un evento muy especial para el intérprete y su hijo, pues ambos colaboran muy activamente con
Miriam Saavedra le calla la boca a Carmen Gahona por reírse de ella en directo
Carmen Gahona es una de las colaboradoras más polémicas de las galas de Supervivientes. Lo cierto es que ha formado una gran amistad con Oriana Marzoli, con la que ha protagonizado algún momento demasiado bochornoso en plató. Esta vez, la que fue pareja de Chiquetete la ha tomado con Miriam Saavedra y esta, como no se queda callada le contestó de una manera que no
Un estudio en ratones demuestra que la segmentación del sistema funcional del intestino ayuda a eliminar patógenos
Un grupo de investigadores de la Universidad de Rockefeller (EE.UU) ha demostrado, en un estudio desarrollado en ratones, que el intestino tiene un sistema funcional organizado en segmentos que permite desarrollar diferentes funciones del sistema inmune en varias partes del órgano y eliminar patógenos, lo que podría ayudar a mejorar los fármacos dirigidos a tratar los trastornos
Bárbara Rey se enfrenta con Marta Roca por la actitud de Chelo en ‘Supervivientes’
Si el comportamiento de Isabel Pantoja está dejando mucho que desear por sus continuas peticiones de que la expulsen, la actitud de Chelo García Cortés está siendo muy cuestionada por todos los espectadores, e incluso por sus compañeros de programa, ya que no entienden por qué es tan servicial con la madre de Kiko Rivera. Lo cierto es que la mujer de Marta
Más de 3.000 pacientes han sido tratados en ensayos clínicos bajo los protocolos de PETHEMA en los últimos 7 años
Más de 3.000 pacientes han sido tratados en ensayos clínicos en los últimos 7 años bajo los protocolos del Programa Español de Tratamientos en Hematología (PETHEMA), el grupo cooperativo de la Sociedad Española de Hematología y Hemoterapia (SEHH). Además, otros 2.300 han recibido tratamientos en estudios posautorización. A día
Isabel Pantoja contra las cuerdas, salvada de la expulsión y con la cabeza en España
Isabel Pantoja está teniendo más suerte que ningún otro concursante. La cantante se salvó durante la noche del martes de la expulsión de esta semana. Recordemos que estaba nominada porque su amigo o el que fue su amigo decidió ponerla directamente en la palestra por su poder de líder, algo que no le sentó nada bien. La tonadillera ha querido explicar
La exposición a la contaminación acorta el embarazo y reduce el tamaño del bebé
La exposición prenatal a la contaminación, a las partículas finas (PM2,5) del aire, acorta el embarazo y disminuye el peso del bebé, según un estudio realizado en ratas por investigadores de la Texas A&M University de Estados Unidos, publicado en la revista 'PNAS', y recogido por la plataforma Sinc. "La exposición materna a partículas finas ultrafinas
‘Noches del Botánico’ llena de música y artistas el verano de Madrid
Sabemos que el calor en los meses de junio y julio es muy agobiante y más aun si no te puedes remojar en las playas españolas. Pero mientras las vacaciones se hacen esperar, te sugerimos un planazo para disfrutar del verano en Madrid. Las Noches del Botánico ha presentado su cuarta edición, que tendrá lugar del 20 de junio al 31 de julio en el Real Jardín Botánico
MSF celebra que la OMS haya aprobado el plan de mejora de la transparencia de los mercados de medicamentos y vacunas
Médicos Sin Fronteras ha celebrado que la Asamblea Mundial de la Salud, organizada por la Organización Mundial de la Salud (OMS), haya aprobado el plan de 'Mejora de la transparencia de los mercados de medicamentos, vacunas y otras tecnologías relacionadas con la salud'. La resolución ha sido liderada por Italia y patrocinada por España y otros 18 países: Andorra,
Un estudio evidencia que la música mejora el desarrollo cerebral de los bebés prematuros
La música mejora el desarrollo cerebral de los bebés prematuros, según un estudio llevado a cabo por expertos de la Universidad de Ginebra (UNIGE) y los Hospitales Universitarios de Ginebra (Suiza) y que ha sido publciado en la revista 'Proceedings of the National Academy of Sciences'. "Afortunadamente conocimos al compositor Andreas Vollenweider, que ya había realizado
La misión Chandra encuentra dúos estelares desterrados de sus galaxias
Observaciones con el telescopio de rayos X Chandra de la NASA han revelado uno de los ejemplos más claros de la expulsión de pares estelares de su base galáctica. Los astrónomos usan el término sistema "binario" para referirse a pares de estrellas que orbitan entre sí. Estos pares estelares pueden consistir en combinaciones de estrellas como nuestro Sol, o
Las personas que nacen muy prematuramente o con bajo peso tienen un alto riesgo de enfermedad pulmonar, según estudio
Las personas nacidas muy prematuramente o con muy bajo peso al nacer tienen un alto riesgo de enfermedad pulmonar y alcanzan su plena capacidad en las vías respiratorias a principios de la edad adulta, según ha demostrado un estudio de la Universidad de Melbourne (Australia). En concreto, esta investigación internacional, publicada en la revista 'The Lancet Respiratory Medicine',
Los nutricionistas aconsejan tomar cada día uno o dos lácteos bajos en grasa
La Academia Española de Nutrición y Dietética, consejo asesor científico del Consejo General de Colegios Oficiales de Dietistas-Nutricionistas (CGCODN), ha aconsejado incluir a diario uno o dos lácteos bajos en grasa, ya sea leche, yogur o quesos, porque contribuye a aportar nutrientes clave, además de cumplir con hábitos alimentarios tradicionalmente arraigados en la dieta mediterránea. El
El Instituto de Salud Carlos III y Gilead anuncian la VII edición de sus Becas a la Investigación Biomédica
El Instituto de Salud Carlos III (ISCIII) y Gilead España han anunciado la convocatoria de las VII Becas Gilead a la Investigación Biomédica. Para la convocatoria de este año, se han destinado 900.000 euros a proyectos en los campos de VIH, Enfermedades hepáticas y Hemato-Oncología, lo que supone un total de 5,6 millones de euros a lo largo de las siete ediciones.
Tortura de presos en la Venezuela chavista
Un extracto del arándano hace que las bacterias sean más sensibles a los antibióticos
Un extracto del arándano hace que las bacterias sean más sensibles a los antibióticos, según ha puesto de manifiesto un estudio llevado a cabo por investigadores de la Universidad McGill y el Instituto Nacional de Investigación Científica en Montreal (Canadá) y que ha sido publicado en la revista 'Advanced Science'. Teniendo en cuenta la creencia popular
Teorizan cómo supernovas alumbraron el bipedismo en los homínidos
Una avalancha de electrones en la atmósfera terrestre provocada por supernovas activó una cadena de eventos que posiblemente desembocó en el 'Homo habilis', primer ser humano bípedo. Los autores de esta nueva teoría, publicada en Journal of Geology, creen que hace 2,6 millones de años, la ionización atmosférica probablemente provocó un enorme aumento de las descargas de nubes a tierra que
El Consejo General de Enfermería entrega los premios ‘FotoEnfermería 2018’
El Consejo General de Enfermería ha hecho entrega de los premios 'FotoEnfermería 2018', resultando ganador Angel Atanasio Rincón, enfermero colegiado en Ciudad Real, quien ha recibido un cheque de 1.000 euros, gracias a su fotografía 'Necesidades básicas'. "Esta fotografía es un homenaje a los orígenes de la profesión. He querido plasmar en una fotografía las necesidades básicas del paciente
Los esteroides reducen el riesgo de cáncer de pulmón hasta un 30% en pacientes con EPOC, según un estudio
Los esteroides pueden reducir hasta en un 30 por ciento el riesgo de cáncer de pulmón en pacientes con enfermedad pulmonar obstructiva crónica (EPOC), según un análisis realizado por investigadores de la Universidad de British Columbia (Canadá). En su trabajo, publicado en la revista 'European Respiratory Journal', los investigadores evaluaron datos médicos
Un dinosaurio tailandés es pariente del T. Rex
Dos nuevas especies de dinosaurios, depredadores eficientes parientes lejanos de T. rex, han sido identificadas ahora en restos fósiles descubiertos hace 30 años en Taliandia. Hace tres décadas, el Museo Sirindhorn recibió unos huesos fosilizados donde nunca fueron examinados en detalle. "Hace cinco años encontré estos hallazgos durante mi investigación",
Los niños con obesidad presentan mayor rigidez arterial al final de la adolescencia, según un estudio
Los niños y adolescentes con obesidad a largo plazo tienen mayor rigidez arterial al final de la adolescencia, según demuestra un estudio de la Universidad de Gotemburgo (Suecia) realizado en más de 3.000 niños seguidos entre los 9 y los 17 años de edad. Su investigación, publicada en la revista 'The Lancet Child & Adolescent Health', utilizó la DEXA (absorción de rayos X de energía dual)
Pilotos de EE.UU. admiten que han visto ovnis
El término objeto volador no identificado, más conocido por el acrónimo ovni según wp, se refiere a la observación de un objeto volador, real o aparente, que no puede ser identificado por el observador y cuyo origen sigue siendo desconocido después de una investigación. Aquellos que sienten fascinación por los objetos voladores no identificados
Recorrido por Huawei en China
Fuente: YT
La mujer de Zapatero se cambia de look a toda prisa tras el cachondeo bestial en Twitter
Las redes no duermen nunca y tinene muy mala leche. El día en que José Luis Rodríguez Zapatero fue elegido secretario general del PSOE, su mujer Sonsoles Espinosa lloró con una mezcla de felicidad y miedo. Hija de un militar atípico en aquellos años de Dictadura (laico, liberal y leído, con una estimable biblioteca heredada por la hija), nunca le han
Una terrible humillación de Letizia al Emérito aceleró el adiós de Don Juan Carlos
Ya les hemos contado al detalle en Periodista Digital los motivos reales del abandono de la vida pública del Rey Emérito Don Juan Carlos. La Casa Real emitía un comunicado, el pasado lunes 27, en el que se contaba su decisión "firme y meditada" de abandonar su actividad institucional a partir del próximo 2 de junio, día en el que se cumplen cinco años
Este ‘salidillo’ comensal de First Dates dice a su cita que necesita tener sexo todos los días
Carlos llegaba al restaurante de las citas de 'First Dates' en Cuatro teniendo muy claro como debe ser la persona con la que compartir su vida. El comensal tiene muy claro que necesita a su lado a una persona a que sea como él y le gusto lo que a él: insaciable en el sexo. El joven afirma que necesita tenerlo todos los días y, a ser posible, que esa persona no sea celosa porque
Carvajal opina sin tapujos sobre Ramos, Hazard y Mbappé
Paula nos muestra sus turgentes ’Echevarrías’ con esta blusa sin sujetador y arrasa en Instagram
Todos sabemos que Paula Echevarría Colodrón (Candás, Carreño, España, 7 de agosto de 1977) es una actriz y modelo española. A finales de la década de los noventa vivió un año en la ciudad de Londres (Reino Unido). En el 2000 inició su andadura en la pequeña pantalla apareciendo en series como Al salir de clase, Policías
Dónde están los políticos honrados
Sobran muchos eminentes letrados, hay abundancia de excelente doctores, hay millares de buenos escritores y personajes muy bien enchufados. También hay ingenieros y abogados y ministerios llenos de asesores, mas lo que nos causa tantos dolores es que no existen políticos honrados. Cuando para investigarlos te agachas, y les levantas un poco la alfombra, lo que en su vida descubres te asombra porque
Jennifer tiene un descuido con una minifalda y nos muestra su depilado “Lopez”
Todos sabemos que Jennifer Lynn Lopez Rodríguez2 (El Bronx, Nueva York, 24 de julio de 1969), más conocida como Jennifer Lopez o J.Lo, es una actriz, cantante, bailarina, compositora, productora discográfica, diseñadora de modas, empresaria, productora de televisión, coreógrafa, perfumista y filántropa estadounidense de origen puertorriqueño (¡Otra
Georgina Rodríguez se calza uno vaqueros y reta a la gravedad con sus delirantes curvas
Buena parte se debe a los genes y la naturaleza (La foto del trasero de Kim Kardashian que podría revelar que esas curvas son todo trampa y cirugía). El resto, al gismnasio y la dieta (Instagram no soporta el trasero de Tracy Sáenz y menos en lencería de encaje). Georgina Rodríguez arrasa en Instagram. La modelo parece que está al margen de lo que su pareja,
Una mujer masturba a su pareja en un restaurante
Una pareja se ha vuelto viral en redes sociales luego de haber protagonizado una escena muy íntima en un restaurante de Honduras. En la grabación que circula por Internet, se observa a una mujer masturbando a su pareja, mientras se asegura de que nadie esté viendo. Sin importar que estén en un lugar público, los enamorados continúan brindando un espectáculo para las personas que se encontraban
Schuster justifica a Ramos: «Él quiere saber a qué nivel va a ir el club»
Temblor natural de las manos para mejorar la calidad de sus imágenes
Fuente: YT
Daniela Ospina luce este mini bañador que deja fuera de juego a James Rodríguez
Todos sabemos que Daniela Ospina Ramírez (Itagüí, 22 de septiembre de 1992) es una jugadora profesional de voleibol y empresaria colombiana. Jugaba para el equipo VP Madrid. Es conocida en la vida pública por haber estado casada con el jugador de fútbol colombiano James Rodriguez, según wp. Daniela Ospina Ramírez nació el 22 de septiembre de
Carvajal opina sin tapujos sobre Ramos, Hazard y Mbappé
Pablo Echenique defiende que Iglesias no se escondió ante el varapalo de Podemos y en Twitter la parten la jeta
Pablo Echenique es un 'crack' en estos mundos de Twitter. Resulta que Pablo Iglesias, que se escondió la noche del 26 de abril de 2019 en algún ignoto rincón del Teatro Goya, sede de la noche electoral de Podemos, para no tener que dar explicaciones del desastre que había cosechado su partido, salió al día siguiente para, supuestamente, dar la cara -Los envenenados
Lo de Isabel Pantoja ya es una vergüenza: Esta es la razón real por la que debería ser expulsada de ‘SV2019’
Lo mejor que le puede pasar a Isabel Pantoja es irse de ‘Supervivientes 2019'. O no. Depende. La tonadillera es la gran estrella del reality de Telecinco pero está empezando a dañar su imagen. Esto es algo muy peligroso si tenemos en cuenta que le queda mucho por hacer a Pantoja en la cadena. Lo que sucedió el martes 28 de mayo de 2019 en la gala de ‘Supervivientes
Salvador Monzó Romero: «Las dos damas»
La Moral y la Política, saltaA la vista que no se llevan bien:Aquella sigue montada en un trenA vapor, y ésta en uno de altaGama, en el que se viaja fetén. En la Política es el insultoArma de fuego con balas de goma,O hasta incluso pluma de palomaEn el sombrero de quien, siendo culto,Si hiere, se considera una broma. En este punto la duda ofende:Quien se lleva la palma es
ASUS Zenbook Pro Duo, el portátil del futuro
Fuente: YT
Àlex Rodenkirchen (Podemos Denia) se cisca en Pablo Iglesias
Monumental rajada del candidato de Podemos en Denia contra Pablo Iglesias: «Coletas, convendría que te callaras la puta boca»
Àlex Rodenkirchen (Podemos Denia) se cisca en Pablo Iglesias. Y a base de bien, además, porque lo ha puesto tibio, que se dice.-- Isa Serra (PODEMOS) pide que no se acepten los 310 millones que Amancio Ortega da para luchar contra el cáncer-- El candidato de la formación morada en la localidad alicantina ha soltado una rajada monumental sobre el líder de Podemos tras
Manuel del Rosal: «España: un Sudoku, un cubo de Rubik»
"Los antiguos godos tenían la costumbre de resolver sus asuntos dos veces: una borrachos y otra serenos. De esta forma unían en sus decisiones el atrevimiento y la prudencia" Los españoles somos muy aficionados a los juegos de azar. Es por eso por lo que, desde que terminó el primer gobierno de Rajoy, hemos convertido a España en un tablero de Sudoku, en un cubo de
Víctor Entrialgo: «La impostura»
Para Aristóteles, la política es lo que distingue al hombre de los animales. En España después de una guerra civil hace casi un siglo, aún seguimos a mitad de camino. Hay que profundizar. Para empezar es preciso reconocer al otro, al otro que no somos nosotros, y a partir de ahi pensar cómo podemos entendernos para conseguir lo mejor para nuestra comunidad.
El escote de Jennifer López en este selfie revienta Instagram
Todos sabemos que Jennifer Lynn Lopez Rodríguez2 (El Bronx, Nueva York, 24 de julio de 1969), más conocida como Jennifer Lopez o J.Lo, es una actriz, cantante, bailarina, compositora, productora discográfica, diseñadora de modas, empresaria, productora de televisión, coreógrafa, perfumista y filántropa estadounidense de origen puertorriqueño.
Por negare a abrocharse el cinturón, 14 turistas británicos son multados en Mallorca
Catorce turistas británicos fueron multados el lunes pasado por negarse a seguir las instrucciones de la tripulación del avión en el que viajaban, una nave de la compañía Jet2 que volaba de Edimburgo a Palma. Según informó la Guardia Civil a Europa Press, los jóvenes se habían negado a abrocharse los cinturones de seguridad y como Pedro
Lady deja a todos ‘Gaga’ con este mini bikini con el que lo enseña todo
Todos sabemos que Stefani Joanne Angelina Germanotta (Nueva York, 28 de marzo de 1986), más conocida por su nombre artístico Lady Gaga, es una cantante, compositora, productora, bailarina, actriz, activista y diseñadora de moda estadounidense. Nacida y criada en la ciudad de Nueva York, estudió en la escuela Convent of the Sacred Heart y asistió por un tiempo breve a la Tisch School of the Arts,
Ignacio Asuaga y todo el equipo de HazteOir.org: «Mi lectura de las elecciones»
Se acabó. Bajó el telón y se apagaron las candilejas electorales hasta dentro de cuatro años (o quién sabe cuándo). De la jornada del domingo, me quedo con la imagen impagable de los pucheros de una demacrada Rita Maestre, la profanadora de capillas, cuyo patetismo vino a certificar la defunción de ese engendro político llamado Podemos que parece
Kim Kardashian se embute dentro de este vestido de látex y parece una rosquilla plastificadada
Todos sabemos que Kimberly Noel Kardashian West (Los Ángeles, 21 de octubre de 1980) conocida como Kim Kardashian, es una empresaria y un personaje público estadounidense de telerrealidad en E! Keeping Up with the Kardashians. Su prominencia aumentó a partir de enero de 2011 con el estreno de Kourtney and Kim Take New York, un reality show que compartió con su hermana Kourtney
Monos designaron una “palabra” especial para nombrar a los drones
Fuente: YT
Mujer se suicida en Madrid tras difundirse un video sexual que grabó hace 5 años
Una mujer llamada Verónica, de 30 años, se suicidó el pasado sábado después de que un video sexual que grabó hace 5 años se difundiera entre gran parte de sus compañeros en una empresa de automoción de Madrid (España) donde trabajan 2.500 empleados, informan medios locales, según rt. A mediados de la semana pasada la mujer,
José Luis Úriz Iglesias: «A pesar de todo es una oportunidad para la izquierda»
Después de una larguísima campaña electoral de más de dos años y tras los sobresaltos de las últimas generales que afortunadamente se superaron sin grandes heridas, llegaba con el 26-M la oportunidad para las izquierdas de rematar la faena. Pero lamentablemente las elecciones europeas, municipales y autonómicas han dejado en el PSOE y la izquierda en
Jugadores y directivos españoles detrás de la ‘Operación Oikos’ sobre partidos amañados
Este martes 28 de mayo de 2019, la Policía española detuvo a nueve jugadores y directivos de la Primera, Segunda y Tercera División de Fútbol por el presunto amaño de partidos a través de apuestas deportivas, en un plan denominado 'Operación Oikos', según rt. En un despliegue simultáneo en cinco ciudades españolas, la Policía
Ex jugador del Real Madrid detenido como supuesto cabecilla de una trama de amaño
Fuenet:YT/RT
El Real Madrid reconfirma que Sergio Ramos ha pedido al club que lo traspasen
El presidente del Real Madrid, Florentino Pérez, ha reconocido que el capitán del equipo, Sergio Ramos, ha pedido al club que lo traspasen, según lo afirmó durante una entrevista radiofónica concedida este lunes a Onda Cero, según rt. "Vino a verme a mi oficina y me dijo que tenía una oferta muy importante de China", explicó Pérez. Asimismo, el presidente del club blanco añadió que el jugador
Un viaje de 360 grados a través de los monasterios de Burgos
Ruinas que suenan a melodías contemporáneas, vida 100% monacal o el esplendor de reinos pasados conforman el día a día en los diferentes monasterios que ´salpican´ la provincia de Burgos. Contacto Travellers @monzonpaul Tanto es así que hoy el interés por rescatar el pasado en algunas de esta ´joyas patrimoniales´ ha cristalizado en
El consejo de Makelele a Mbappé que no va a olvidar
¡Palabras de galáctico..1. .Claude Makelele, le ha transmitido un consejo a Kylian Mbappé después de que declarara que necesita tomar más responsabilidades en el PSG o en un nuevo proyecto. El ex jugador del Real Madrid, en una entrevista a Le Parisien, comentó que no existe edad para tomar responsabilidades. Por tanto, deben dársela. Pero luego debe
Este adorable uómbat se rasca el culo al ritmo del ‘wiggle, wiggle’
Un excursionista australiano que atravesaba la montaña Cradle, en Tasmania, se topó con un adorable uómbat que intentaba aliviarse el picor de su trasero con un escalón de madera, según rt. El autor del video, Piotr Babis, bajaba la escalinata cuando se topó con el torpe marsupial, que le bloquea el paso mientras continúa 'bailando', ignorando por completo
Este adorable uómbat se rasca el culo al ritmo del ‘wiggle, wiggle’
Fuente:Instagram
Arriesga su vida para salvar a dos niñas de un balcón en llamas
Un valiente joven rescató el lunes a dos niñas atrapadas por un incendio en el balcón de un edificio, según rt. El siniestro se produjo en un edificio de la ciudad de Fókino, en la región de Primorie del Lejano Oriente de Rusia. Las llamas se propagaron tan rápido que dos niñas, de 12 y 3 años de edad, se vieron obligadas a refugiarse en
Arriesga su vida para salvar a dos niñas de un balcón en llamas
Fuente: YT
Graban a estos 5 policías indios dándole una paliza a una mujer con un cinturón
La Policía del estado indio de Haryana ha suspendido a dos oficiales y despedido a otros tres, dos de los cuales se encuentran detenidos, luego de viralizarse en las redes un video en el que aparecen golpeando con un cinturón a una mujer en la ciudad de Faridabad, informa la cadena local NDTV, según rt.
Graban a estos 5 policías indios dándole una paliza a una mujer con un cinturón
Fuente:YT/RT
¡De parvulario! Un secretario de Estado de Sánchez llama «homófobos» a los de Vox y luego borra el tuit
Le han pillado con el carrito del helado, aunque está claro que tampoco muestra un sincero y arrepentimiento. Francisco Polo, que es secretario de Estado de Agenda Digital en el Gobierno de Pedro Sánchez, está con cierto resquemor por los resultados de la noche electoral del 26 de mayo de 2019 sobre todo porque en muchas instituciones entrará de una u otra manera el partido
Destinos de turismo espacial celebran el 50 aniversario de la llegada del hombre a la Luna
Este año se cumple un aniversario importante en la historia de la carrera espacial y es que el 20 de julio de 2019 se celebran los 50 años desde que el módulo "Aguila Lunar" del Apolo 11 aterrizase en la Luna. Ese día los astronautas estadounidenses Neil Armstrong y Buzz Aldrin fueron los primeros hombres en pisar la superficie lunar, y el famoso "pequeño paso" de
Cachondeo en la redes por los gemidos de Violeta en su loca noche de sexo en ‘Supervivientes’
La noche de sexo y pasión entre Fabio y Violeta ha resultado la mas caliente de toda la historia de 'Supervivientes'. Los concursantes daban rienda suelta a la pasión sin importarles que estuvieran siedno grabados por las cámaras del program. Los tortolitos no se cortaban nada y mantenian unas sonoras relaciones sexuales en la silenciosa noche caribeña dejando, ya para la
Robots capaz de trabajar con humanos, detectan sus movimientos
Fuente: YT
‘Mannequin challenge’: entrenamiento para desarrollar algoritmos
Los desarrolladores de Google Research le han enseñado a un algoritmo a crear un mapa de profundidad en videos, en el que se mueven tanto las personas como la cámara. Esto puede ayudar a crear aplicaciones para teléfonos inteligentes que pueden, por ejemplo, cambiar la profundidad del campo en los anuncios, dicen los autores en el blog de Google AI. El mapa de profundidad es una imagen en la que
¿Qué compañía aérea tiene la “Mejor Clase Business del Mundo»?
Qsuite, la galardonada experiencia en Clase Business de Qatar Airways, estará disponible en los vuelos de Málaga a partir del 1 de junio 2019. Este exclusivo asiento llega justo un año después de que se iniciaran las operaciones entre Málaga y Doha. La ruta estacional se reanuda del 29 de mayo de 2019 hasta el 29 de septiembre de 2019, y se incrementa a cinco vuelos por semana en un Boeing 777-200,
El doloroso momento en que este torero francés recibe una cornada en el recto
El francés Juan Leal fue corneado este sábado en la zona del recto cuando toreaba en la plaza de toros de Las Ventas de Madrid (España) con motivo de la Feria de San Isidro, según se aprecia en un video publicado en YouTube, según rt. La grabación recoge el momento exacto en que el toro empitona por detrás al torero, que se eleva por los aires antes
¿Cuál es el destino favorito para los amantes de la navegación en España?
Click&Boat, la principal plataforma online de reservas de embarcaciones de recreo, ha analizado el mercado de embarcaciones recreativas en España y concluye que Baleares es el principal destino para los viajeros que buscan planes y actividades relacionadas con la navegación, según muestran los datos transaccionales de su sistema de reservas. Contacto Travellers @monzonpaul Además, las reservas
Luca Costantini (VozPopuli): «Carmena fue una alcaldesa que solo gobernó para los hipsters de Malasaña»
Uno de cada cuatro votos que perdió Más Madrid con respecto a 2015 fueron de este distrito, donde más creció la abstención. La falta de limpieza, Madrid Central, y problemas de convivencia, clave en la bajada. De los 20.396 votos que perdió Más Madrid en las elecciones del 26-M con respecto a las de 2015, 5.400 se fueron por el desagüe de Puente
PULL&BEAR y el PRIMAVERA SOUND revolucionan el concepto ‘festivalero’
Este no es un año cualquiera. Las nuevas generaciones cada vez somos más conscientes de (y con) todo lo que nos rodea. Y eso se transmite hasta extremos inimaginables: nuestros queridos festivales. Mañana arranca de manera oficial, el Primavera Sound 2019, la edición para la que el festival y Pull&Bear presentan su alianza #PSxPULLANDBEAR. Un concepto que no solo implica
KIT HARINGTON (o Jon Nieve en la ficción) ingresa en un centro de rehabilitación
El actor británico que encarnaba a Jon Nieve en la famosa saga Juego de Tronos ha decidido ingresar en un centro de rehabilitación para poder tratar sus problemas (tanto con la bebida, como con el estrés que sufría desde el rodaje de la última temporada de la serie). Y es que, según han declarado sus agentes para algunos medios británicos: "Kit ha decidido
Luca Constantini en El Quilombo: «Carmena fue una alcaldesa solo para los hipsters de Malasaña»
Uno de cada cuatro votos que perdió Más Madrid con respecto a 2015 fueron de este distrito, donde más creció la abstención. La falta de limpieza, Madrid Central, y problemas de convivencia, clave en la bajada. De los 20.396 votos que perdió Más Madrid en las elecciones del 26-M con respecto a las de 2015, 5.400 se fueron por el desagüe de Puente de Vallecas. Aquí se fraguó la derrota de Carmena,
Fran Rivera aconseja a las chicas que se cuiden de enviar vídeos sexuales para evitar disgustos y la turba feminista se abalanza a desearle la muerte
Es una tragedia terrible el desenlace de la vida de la joven Verónica Rubio, que se suicidó tras distribuirse en su empresa un vídeo sexual de cinco años atrás. Deja dos niños muy pequeños y un marido, y sobre todo, una agresión imperdonable de cada uno de los viralizadores de estos contenidos. Ahora están siendo investigados y todo el que pasara el vídeo dentro y fuera de la empresa Iveco
Sergio Espí parodia a Pantoja y Chelo García Cortés
Fran Rivera opina sobre el vídeo sexual y la lía parda
Periodista Digital estrena ‘Mátame camión’, una tertulia canalla sobre TV y ‘corazoneo’ que podrás seguir en directo
Periodista Digital sigue adelante con paso firme en la creación de contenidos y este jueves 30 de mayo de 2019 estrena 'Mátame Camión', un programa absolutamente loco y sin filtros con la televisión y el mundo del corazón como excusa. Después del ya consolidado y creciente 'El Quilombo', la parrilla de televisión en internet en directo del periódico se amplía con este nuevo espacio, que arrancará
Este periodista se come el diario en el que había ninguneado al campeón mundial de hockey sobre hielo
El periodista finlandés Filip Saxén se ha grabado mientras mastica una hoja de periódico con un artículo suyo en el que minusvaloró duramente a la selección de hockey sobre hielo de este país, disculpándose de esta forma por sus palabras después que el combinado ganara el Campeonato Mundial, según rt. "Antes del campeonato, había